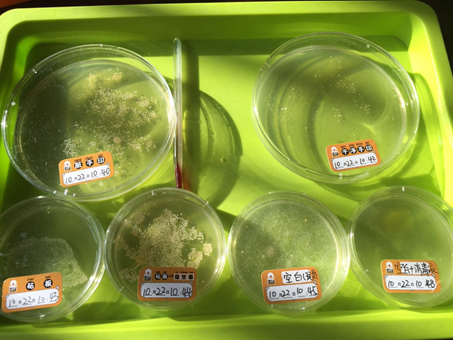
20180109132647812003.png

在孩子们的世界里:星星和天空可以诉说秘密,彩虹和蜡笔可以装进书包里…他们的世界总是充满了童真和快乐,同时也充斥着想象力和创造力。因为单纯,孩子们的世界是简单的,因为简单,也才有了更加纷繁的世界等待着他们去探索。

1月6日,上海市静安区小学生创意设计节“萌创公益”在悦达889 plaza拉开帷幕。“发明源于生活,创意改变生活”,今年的创意设计活动更是源于对生活的精准洞察,立足孩子们越发不可估量的创造力以及萌宠家庭新潮流来呼唤设计灵感,鼓励孩子们以更具创造性的方式谱写成长日记。
滴露玩出新花招,首席探索官玩转创意工坊
本次“萌创公益”可谓创意迭出,惊喜连连。不仅有专业大咖助阵亲身指导小朋友开展专业设计,更有小朋友们展示出的惊人创造力和作品。作为活动的合作优秀伙伴们,在本次以“创造力”为主题的设计节上,也更加展示出有创造力的看家本领。

滴露,作为一直守护小朋友们健康的除菌卫士,以除菌专家的身份广为小朋友和家长所熟悉。在本次设计节中,滴露更是玩出新的高度:不仅在现场精心设计了互动装置,让小朋友们直接体验滴露产品的神奇曼妙,更化身创意工坊的实验材料与小朋友们见面。在模拟喷雪、火焰掌等趣味实验中,滴露产品化身重要道具,在滴露首席探索官的巧妙操作下,最终呈现给小朋友们WOW的视觉效果。
在设计节现场,滴露通过培养皿向到场的爸爸妈妈们及小朋友们展示了日常生活中无处不在却又容易被忽视的细菌,透过培养皿可以清晰看到手上、玩具上以及小朋友们日常接触到的物体上面所附着的细菌,震撼的视觉冲击给小朋友们上了一场生动的卫生保健课。对于滴露而言,换个角度走进孩子们的视角可谓别出心裁;对于品牌营销而言,真正融入场景与消费者真实互动,才是更加有效的方式和思路。
专业除菌用滴露,为孩子们探索世界保驾护航
越来越多的辣妈潮爸追赶起”三人一狗“的生活潮流,让萌娃和萌宠一起探索世界,携手成长。 除了和宠物相处,孩子生活的方方面面都面临着细菌的威胁。因为爱探索的天性,他们会没有丝毫戒备心地和宠物亲近,DIY一件新鲜或陌生的事物。对于爸爸妈妈而言,内心的担忧和纠结像个天枰一样摇摆不定,既担心孩子受到细菌的侵袭,又不忍心扼杀孩子勇于探索的热情和童心,而滴露恰好在这一刻挺身而出,扮演了守护者的角色。

从小培养孩子爱洗手的好习惯,对于阻隔宠物以及各种玩具所携带的细菌病毒有着至关重要的作用。滴露洗手液主要分为抑菌洗手液和泡沫洗手液,其中泡沫洗手液以其5秒杀菌的强大功能和犹如棉花糖般的细腻,能够深入肌肤毛孔清洁,特别适用于儿童。坚持洗手并使用专业的洗手液可以为孩子们保驾护航,让爸爸妈妈放手孩子也无妨。滴露消毒液可以有效杀灭99.999%以上的肠道致病菌、化脓性球菌、 致病性酵母菌,经过合适的比例稀释后,可以有效应对孩子的玩具、衣物消毒以及宠物家庭的日常杀菌消毒。

滴露品牌面世已有80多年,自从品牌成立之日起,一直都在帮助世界各地的家庭守护健康,也越来越多得到世界各地消费者的认可,守护孩子们无忧玩乐让孩子们尽情探索,将成为滴露产品新的使命和动力。
















